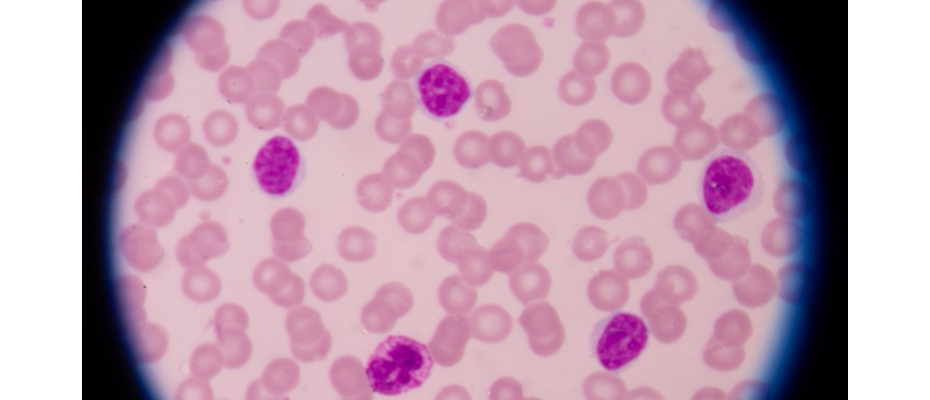

Chronic Lymphocytic Leukemia is a type of cancer affecting mature B cells, an essential component of our immune system. In some patients, the disease progresses slowly and remains stable for years, while in others it becomes aggressive. A particularly severe development is Richter Transformation, where this tumour evolves into a fast-growing lymphoma. Understanding the molecular factors behind these different disease courses is crucial for improving patient care and guiding treatment.
A recent study published in Frontiers investigated how MYC, a gene that regulates cell growth, division and survival, influences disease progression in Chronic Lymphocytic Leukemia and Richter Transformation. The work was led by the Biomedical Genomics Group at CNAG, under the direction of Ivo Gut, with contributions from Maria Tsagiopoulou, who conducted part of this research while at CNAG. The study focused on how the activation of genes controlled by MYC affects tumor behavior and clinical outcomes.
To explore this, the researchers analysed hundreds of patient samples from publicly available projects. This included bulk RNA sequencing, which measures the overall gene activity in tumor samples, and paired samples taken from the same patients before and after Richter Transformation, allowing direct observation of changes as the disease progressed. They also studied over 40.000 individual cells using single-cell RNA sequencing, capturing both tumor cells and surrounding immune cells. Combining these datasets, the team created a signature of 285 MYC target genes, providing a detailed picture of MYC activity at different stages of the disease.
The results showed that MYC activity is higher in Chronic Lymphocytic Leukemia cases with more aggressive characteristics and further increases during Richter Transformation. These findings suggest that MYC not only drives tumor growth but also shapes the interactions between cancer cells and their microenvironment, supporting disease progression.
Overall, this study highlights MYC as a central driver of aggressive CLL progression. By mapping MYC activity across patients and disease stages, the research offers new insights into which patients may be at higher risk of rapid progression and points toward potential strategies for personalised treatment. This work also helps our understanding of leukemia biology and provides a foundation for future therapeutic developments targeting MYC.
Tsagiopoulou M, Rashmi S, Chatziaslani M and Gut I (2025) MYC target gene activation in chronic lymphocytic leukemia and richter transformation: links to aggressiveness and tumor microenvironment interactions. Front. Pharmacol.16:1642458. doi: 10.3389/fphar.2025.1642458











